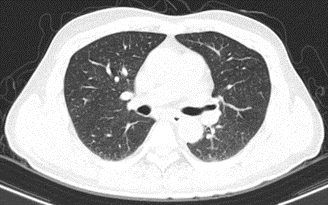

Các phương pháp điều trị ung thư gan
Hiện nay, điều trị ung thư gan nguyên phát bao gồm nhiều phương pháp khác nhau tùy thuộc vào giai đoạn bệnh và thể trạng người bệnh. Phẫu thuật vẫn giữ vai trò chủ đạo trong điều trị bệnh ở giai đoạn khu trú. Bên cạnh đó, các phương pháp như nút mạch (TACE), đốt sóng cao tần, tiêm cồn, xạ trị, hóa trị triệu chứng, điều trị giảm đau – chăm sóc giảm nhẹ, điều trị đích và xạ trị chiếu trong bằng hạt vi cầu phóng xạ cũng được áp dụng.
Đối với các trường hợp UTBMTBG tiến triển, không còn chỉ định phẫu thuật hoặc các biện pháp can thiệp tại chỗ, điều trị toàn thân là lựa chọn phù hợp.
Trong số các liệu pháp toàn thân, Atezolizumab và Bevacizumab là hai thuốc có cơ chế tác dụng khác nhau nhưng mang lại hiệu quả khi phối hợp. Atezolizumab là thuốc ức chế điểm kiểm soát miễn dịch, tác động lên PD-L1, giúp hệ miễn dịch nhận diện và tiêu diệt tế bào ung thư. Trong khi đó, Bevacizumab là thuốc ức chế VEGF, ngăn chặn sự hình thành mạch máu nuôi khối u, từ đó làm chậm sự phát triển của ung thư. Nhiều nghiên cứu cho thấy, sự kết hợp hai thuốc này giúp cải thiện thời gian sống thêm không bệnh ở bệnh nhân UTBMTBG giai đoạn muộn hoặc tái phát.

Hình 1: Hình ảnh chụp cắt lớp vi tính ổ bụng: Nhu mô hạ phân thùy S7-8 có khối (vòng tròn đỏ) tỷ trọng hỗn hợp kích thước 81x51mm gồm phần tăng tỷ trọng của vật liệu can thiệp và nhiều bóng khí tạo thành ổ tụ khí trong nhu mô kèm phần hoại tử dạng dịch, không có huyết khồi.
Trình bày ca lâm sàng
Bệnh nhân Đ.H.M., nam, 65 tuổi, nhập viện tháng 10/2023 do sốt và đau vùng hạ sườn phải. Bệnh nhân có tiền sử viêm gan B mạn tính, đang điều trị bằng Tenofovir 300 mg/ngày; gia đình không ghi nhận tiền sử ung thư.
Người bệnh được chẩn đoán UTBMTBG từ năm 2019 và đã trải qua 6 lần nút mạch (3 lần tại Bệnh viện K Tân Triều và 3 lần tại Bệnh viện Đa khoa Thái Nguyên). Sau lần TACE thứ 6 vào tháng 10/2023, bệnh nhân xuất hiện đau nhiều vùng hạ sườn phải kèm sốt, được chẩn đoán áp xe gan và điều trị nội khoa ổn định trước khi chuyển đến Trung tâm Y học hạt nhân và Ung bướu – Bệnh viện Bạch Mai.
Tình trạng khi nhập viện
Bệnh nhân tỉnh táo, thể trạng trung bình (cao 165 cm, nặng 60 kg), chỉ số toàn trạng PS = 0. Khám lâm sàng chưa ghi nhận bất thường đáng kể. Các xét nghiệm cơ bản trong giới hạn bình thường, tuy nhiên AFP tăng rất cao (648,1 ng/ml).
Chẩn đoán xác định: Ung thư biểu mô tế bào gan BCLC B, đã TACE 6 lần – xơ gan Child-Pugh A – viêm gan B.
Quá trình điều trị và theo dõi
Sau hội chẩn hội đồng ung thư tiêu hóa, bệnh nhân được chỉ định điều trị theo phác đồ Atezolizumab – Bevacizumab, chu kỳ 21 ngày:
Atezolizumab 1.200 mg truyền tĩnh mạch ngày 1
Bevacizumab 15 mg/kg truyền tĩnh mạch ngày 1
Trong quá trình điều trị, bệnh nhân dung nạp thuốc tốt, không ghi nhận tác dụng phụ nghiêm trọng. Người bệnh không mệt mỏi, không đau bụng, ăn uống tốt, tăng 3 kg và sinh hoạt bình thường.
Nồng độ AFP giảm rõ rệt qua các mốc theo dõi: từ 648,1 ng/ml (10/2023) xuống còn 9,2 ng/ml (3/2025) sau 20 chu kỳ điều trị, tiệm cận giới hạn bình thường.
Hình 2: Hình ảnh chụp cắt lớp vi tính lồng ngực: Không thấy các tổn thương thứ phát
Đánh giá hình ảnh học
Các lần chụp cắt lớp vi tính ổ bụng cho thấy khối u gan giảm kích thước đáng kể, không còn tăng sinh mạch, không có huyết khối. Kích thước u giảm từ 81 x 51 mm ban đầu xuống còn khoảng 22 x 45 mm sau 20 chu kỳ điều trị.
Theo tiêu chuẩn RECIST 1.1, bệnh nhân đạt đáp ứng một phần (PR – Partial Response).
Kết luận và hướng điều trị
Đây là trường hợp UTBMTBG giai đoạn BCLC B, đã điều trị TACE nhiều lần, xơ gan Child-Pugh A và viêm gan B, đạt đáp ứng rất tốt với phác đồ Atezolizumab – Bevacizumab. Điều trị giúp khối u thu nhỏ rõ rệt, chỉ số AFP giảm mạnh, đưa bệnh nhân từ giai đoạn không còn khả năng phẫu thuật trở lại nhóm có thể xem xét can thiệp phẫu thuật.
Trong thời gian tới, bệnh nhân tiếp tục được duy trì phác đồ Atezolizumab – Bevacizumab, đồng thời theo dõi sát để phát hiện sớm các thay đổi bất thường, hướng tới tối ưu hóa hiệu quả điều trị lâu dài.




